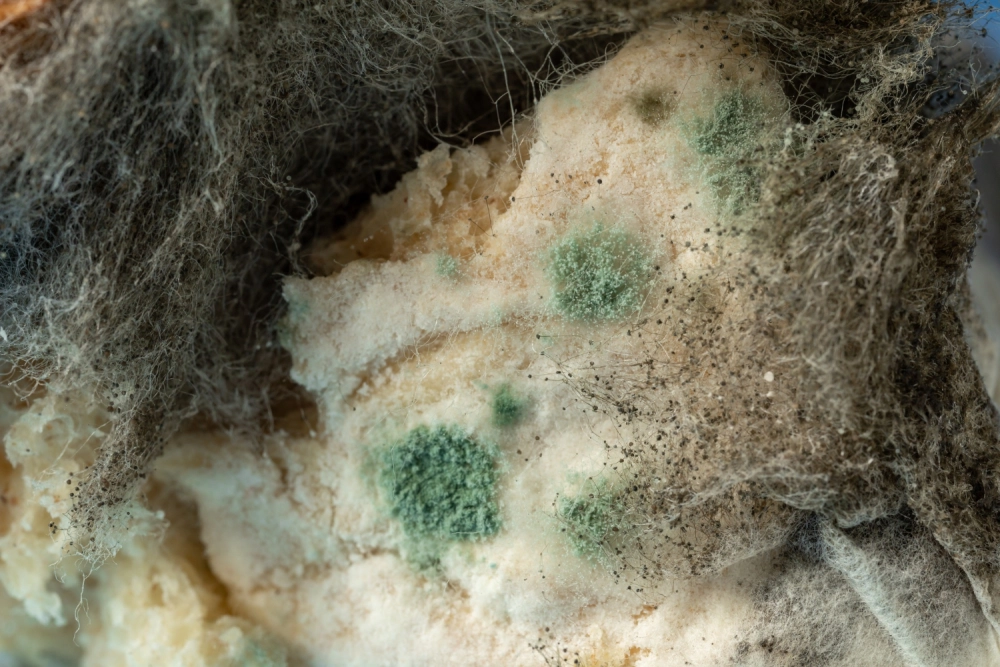
Nấm mốc bánh mì có ăn được không là câu hỏi lớn

Khi nấm mốc bánh mì soi kính được đặt dưới ống kính, thế giới tí hon hiện ra với màu sắc và cấu trúc gây sốc. Ảnh nấm mốc bánh mì soi kính khiến người xem không tin vào những gì mắt thường từng thấy.
Nấm mốc bánh mì soi kính nhìn như thế nào?
Nấm mốc bánh mì soi kính hiện lên với những sợi nấm dài mảnh, các cụm bào tử tròn và mảng màu xanh đen loang lổ. Ảnh nấm mốc bánh mì soi kính giúp người xem thấy rõ từng chi tiết ghê rợn nhưng đầy cuốn hút trong thế giới tí hon.

>>> Xem thêm: Chiêm ngưỡng đầu bút bi phóng to cùng những chi tiết kỳ lạ
Tổng hợp ảnh nấm mốc bánh mì soi kính sắc nét
Ảnh nấm mốc bánh mì soi kính ghi lại từng đốm vi sinh vật phóng đại nhiều lần, từ sợi nấm mảnh như tơ đến cụm bào tử thô ráp. Nấm mốc bánh mì soi kính qua nhiều mức phóng đại tạo nên sự cuốn hút mạnh nhờ màu sắc và chi tiết lạ lùng.







>>> Click để xem ngay: Khám phá con chấy soi kính - Sinh vật ký sinh trên da đầu

Kết luận
Nấm mốc bánh mì soi kính không chỉ rùng mình mà còn mở ra góc nhìn độc đáo về vi sinh. Ảnh nấm mốc bánh mì soi kính khiến người xem tò mò hơn. Hãy tiếp tục khám phá thêm nhiều chủ đề ảnh thế giới tí hon để mở rộng góc nhìn.